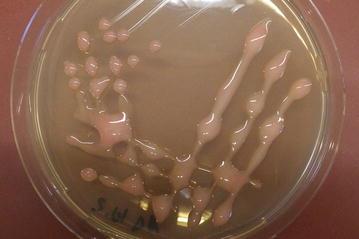
https://cdn.ncbi.nlm.nih.gov/pmc/blobs/7b5e/5471672/ee204429f33e/13104_2017_2538_Fig1_HTML.jpg

从一颗感染牙齿的根管中分离出的黏膜玫瑰单胞菌的特性研究。
Characterisation of Roseomonas mucosa isolated from the root canal of an infected tooth.
作者信息
Diesendorf Nina, Köhler Stefanie, Geißdörfer Walter, Grobecker-Karl Tanja, Karl Matthias, Burkovski Andreas
机构信息
Friedrich-Alexander-Universität Erlangen-Nürnberg, Professur für Mikrobiologie, Staudtstr. 5, 91058, Erlangen, Germany.
Friedrich-Alexander-Universität Erlangen-Nürnberg, Universitätsklinikum ErlangenMikrobiologisches Institut-Klinische Mikrobiologie, Immunologie und Hygiene, Wasserturmstr. 3-5, 91054, Erlangen, Germany.
出版信息
BMC Res Notes. 2017 Jun 14;10(1):212. doi: 10.1186/s13104-017-2538-4.
OBJECTIVE
The genus Roseomonas comprises a group of pink-pigmented, slow-growing, aerobic, non-fermentative Gram-negative bacteria, which have been isolated from environmental sources such as water and soil, but are also associated with human infections. In the study presented here, Roseomonas mucosa was identified for the first time as part of the endodontic microbiota of an infected root canal and characterised in respect to growth, antibiotic susceptibility and biofilm formation.
RESULTS
The isolated R. mucosa strain showed strong slime formation and was resistant to most β-lactam antibiotics, while it was susceptible to aminoglycosides, carbapenemes, fluorochinolones, polymyxines, sulfonamides and tetracyclines. Biofilm formation on artificial surfaces (glass, polystyrene, gutta-percha) and on teeth was tested using colorimetric and fluorescence microscopic assays. While solid biofilms were formed on glass surfaces, on the hydrophobic surface of gutta-percha points, no confluent but localised, spotty biofilms were observed. Furthermore, R. mucosa was able form biofilms on dentin. The data obtained indicate that R. mucosa can support establishment of endodontic biofilms and furthermore, infected root canals might serve as an entrance pathway for blood stream infections by this emerging pathogen.
目的
玫瑰单胞菌属包含一组粉红色色素沉着、生长缓慢、需氧、非发酵的革兰氏阴性菌,它们已从水和土壤等环境来源中分离出来,但也与人类感染有关。在本研究中,黏膜玫瑰单胞菌首次被鉴定为感染根管牙髓微生物群的一部分,并对其生长、抗生素敏感性和生物膜形成进行了表征。
结果
分离出的黏膜玫瑰单胞菌菌株表现出强烈的黏液形成,对大多数β-内酰胺类抗生素耐药,而对氨基糖苷类、碳青霉烯类、氟喹诺酮类、多粘菌素类、磺胺类和四环素类敏感。使用比色法和荧光显微镜检测法测试了在人工表面(玻璃、聚苯乙烯、牙胶)和牙齿上的生物膜形成。虽然在玻璃表面形成了固态生物膜,但在牙胶尖的疏水表面上,未观察到融合的而是局部的、点状生物膜。此外,黏膜玫瑰单胞菌能够在牙本质上形成生物膜。所获得的数据表明,黏膜玫瑰单胞菌可以支持牙髓生物膜的形成,此外,感染的根管可能是这种新兴病原体进入血流感染的途径。